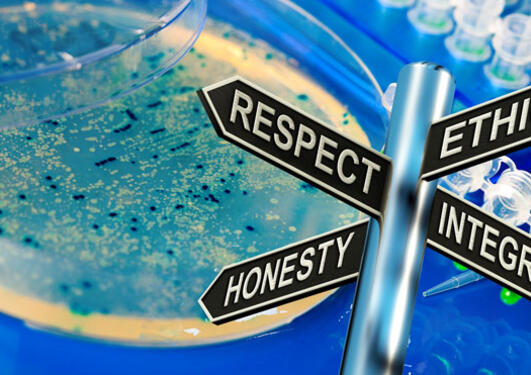

News archive for Centre for the Study of the Sciences and the Humanities
The Council of Europe, with its 47 member states, has for years been involved in international efforts for human rights and bioethics. In particular, it is known for the so-called Oviedo Convention that outlines ethical principles for biomedicine.
- June 2026 (1)
- February 2026 (1)
- November 2025 (1)
- July 2025 (1)
- June 2025 (1)
- January 2025 (2)
- November 2024 (1)
- September 2024 (1)
- February 2024 (1)
- October 2023 (1)
- September 2023 (1)
- April 2023 (1)
- March 2023 (1)
- January 2023 (2)
- October 2022 (1)
- August 2022 (1)
- May 2022 (1)
- April 2022 (2)
- February 2022 (3)
- January 2022 (1)
- December 2021 (1)
- November 2021 (2)
- October 2021 (1)
- September 2021 (2)
- August 2021 (2)
- June 2021 (1)
- May 2021 (3)
- April 2021 (1)
- March 2021 (3)
- January 2021 (1)
- December 2020 (1)
- November 2020 (2)
- October 2020 (2)
- September 2020 (3)
- July 2020 (2)
- June 2020 (2)
- April 2020 (1)
- February 2020 (1)
- November 2019 (1)
- October 2019 (3)
- June 2019 (1)
- May 2019 (1)
- October 2018 (1)
- June 2018 (1)
- April 2018 (1)
- February 2018 (1)
- November 2017 (1)
- June 2017 (1)
- May 2017 (1)
- October 2016 (1)
- January 2016 (1)
- April 2015 (1)
- September 2014 (1)